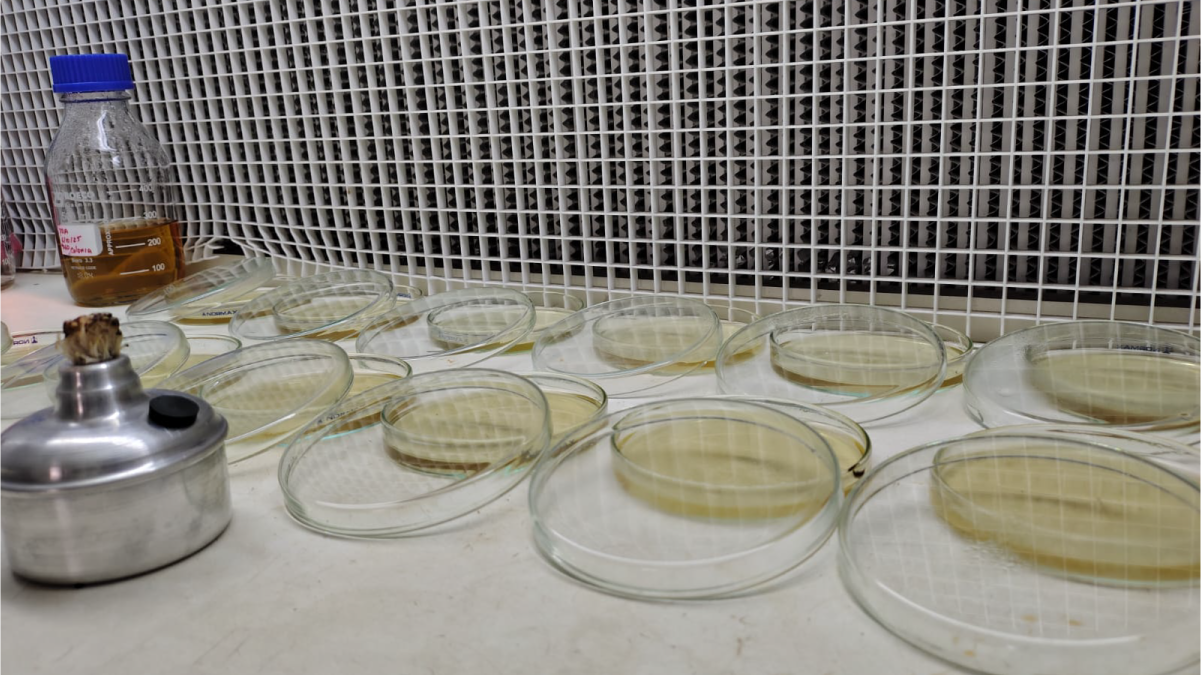

Investigación pionera sobre la calidad de alimentos caninos
El programa de Zootecnia de Fusagasugá evalúa la calidad, inocuidad y digestibilidad de las dietas comerciales para perros del mercado local.
Por: Alejandro García Suárez – Oficina Asesora de Comunicaciones
La alimentación de los perros en Fusagasugá enfrenta importantes desafíos en calidad, inocuidad y valor nutricional. Por esta razón, el programa de Zootecnia de la Universidad de Cundinamarca sede Fusagasugá, desarrolla una investigación pionera que evalúa la digestibilidad, calidad microbiológica y fisicoquímica de las dietas comerciales para caninos disponibles en el mercado local.
Ana María Colonia Pineda, Gestora del Conocimiento y el Aprendizaje del programa de Zootecnia en Fusagasugá, lidera este proyecto que ya ha arrojado hallazgos importantes. Las dietas semiprocesadas, percibidas por los tutores como más "naturales", presentan mayor riesgo microbiológico con la detección de Salmonella spp., E. coli, coliformes, mohos y levaduras.
"Estos hallazgos implican un riesgo sanitario y zoonótico significativo que debe ser atendido con urgencia", señaló la investigadora, destacando que la salud de las mascotas y sus tutores puede verse comprometida.
Inconsistencias en productos ultraprocesados
Por su parte, Yandy Johanna Aguillón Páez, Gestora del Conocimiento y el Aprendizaje, explicó que las dietas ultraprocesadas, a pesar de estar sometidas a mayores controles industriales, presentan inconsistencias entre la información declarada en las etiquetas y su composición real. Esta situación, señaló, puede afectar la digestibilidad y biodisponibilidad de los nutrientes, influenciada por factores como la calidad de las materias primas, los procesos de fabricación y reacciones químicas como la de Maillard.
El estudio revela que ambos tipos de dietas requieren mayor vigilancia regulatoria, estudios independientes y lineamientos técnicos que aseguren productos inocuos, trazables y nutricionalmente adecuados. La investigación tiene como objetivo general "evaluar dietas comerciales ultra-procesadas y dietas semi-procesadas para perros a través de la digestibilidad in vitro, calidad microbiológica y fisicoquímica en el municipio de Fusagasugá, Cundinamarca".
El proyecto desarrolla tres líneas específicas de trabajo: determinar la digestibilidad gastrointestinal in vitro en el laboratorio de nutrición de la UCundinamarca, caracterizar la calidad fisicoquímica y microbiológica en los laboratorios institucionales, y producir información científica para divulgación masiva sobre el uso adecuado y seguro de estas dietas.
Los análisis se realizan en los laboratorios especializados de la Universidad de Cundinamarca, utilizando técnicas de digestibilidad in vitro que simulan el proceso digestivo canino. Esta metodología permite evaluar con precisión la capacidad de los alimentos para liberar nutrientes disponibles para el organismo.
Los estudios microbiológicos identifican patógenos y contaminantes, mientras que las pruebas fisicoquímicas verifican la composición declarada versus la real de los productos comerciales.
Esta investigación busca proteger la salud y bienestar de los caninos, reduciendo riesgos para sus tutores. El proyecto se alinea con los Objetivos de Desarrollo Sostenible en seguridad alimentaria y salud pública, reconociendo que la alimentación animal impacta directamente en la convivencia humano-animal.
"Necesitamos generar información científica independiente que permita a los tutores tomar decisiones informadas sobre la alimentación de sus mascotas", enfatizó Colonia Pineda.
Estefanía Vasco Hortúa, estudiante de séptimo semestre de Zootecnia e integrante del proyecto, destacó que esta experiencia ha sido significativa en su proceso de formación académica. “Me ha permitido integrar los conocimientos teóricos adquiridos durante la carrera con la práctica científica en laboratorio, comprendiendo de manera más real la relación entre la nutrición, la calidad de los alimentos y la salud animal. Además, me ha ayudado a reconocer que la zootecnia no se limita a bovinos, equinos, porcinos o aves, sino que abarca otras especies que también merecen nuestra atención y en las cuales podemos aplicar nuestros conocimientos”, afirmó la estudiante.
Un componente fundamental del proyecto es la producción de información científica accesible mediante herramientas digitales y divulgación masiva. Los resultados se comunicarán a través de guías prácticas, infografías y contenidos educativos que orienten a los tutores de mascotas sobre la selección adecuada de alimentos. Esta estrategia democratiza el conocimiento científico y empodera a la comunidad para exigir productos de mayor calidad en el mercado.
Este proyecto demuestra el compromiso de la Universidad de Cundinamarca con la investigación aplicada que responde a problemáticas reales del territorio. La Facultad de Ciencias Agropecuarias fortalece su línea de investigación en nutrición animal, generando conocimiento pertinente que impacta positivamente en la calidad de vida de las mascotas y sus familias en Fusagasugá y la región.
Escucha nuestro Podcast: